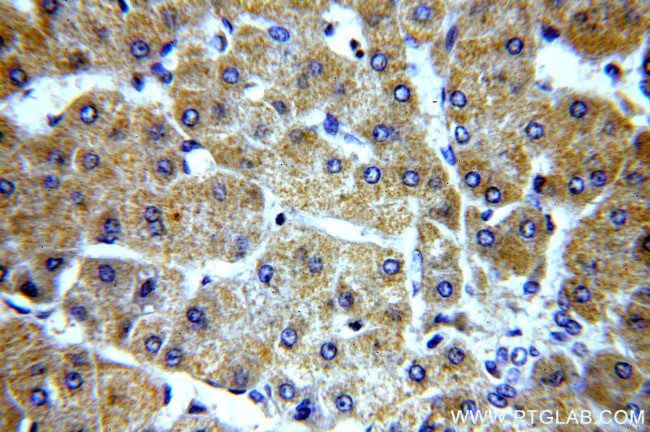
ELOVL2 Antibody in Immunohistochemistry (Paraffin) (IHC (P))

Search
Proteintech
ELOVL2 Polyclonal Antibody
{{$productOrderCtrl.translations['antibody.pdp.commerceCard.promotion.promotions']}}
{{$productOrderCtrl.translations['antibody.pdp.commerceCard.promotion.viewpromo']}}
{{$productOrderCtrl.translations['antibody.pdp.commerceCard.promotion.promocode']}}: {{promo.promoCode}} {{promo.promoTitle}} {{promo.promoDescription}}. {{$productOrderCtrl.translations['antibody.pdp.commerceCard.promotion.learnmore']}}
产品信息
20308-1-AP
种属反应
宿主/亚型
分类
类型
抗原
偶联物
形式
浓度
规格
纯化类型
保存液
内含物
保存条件
运输条件
产品详细信息
Immunogen sequence: LLSAYMLAE LILSTWEGGY NLQCQDLTSA GEADIRVAKV LWWYYFSKSV EFLDTIFFVL RKKTSQITFL HVYHHASMFN IWWCVLNWIP CGQSFFGPTL NSFIHILMYS (77-185 aa encoded by BC050278)
靶标信息
ELOVL2 could be implicated in tissue-specific synthesis of very long chain fatty acids and sphingolipids. This protein may catalyze one or both of the reduction reaction in fatty acid elongation, i. e., conversion of beta-ketoacyl CoA to beta-hydroxyacyl CoA or reduction of trans-2-enoyl CoA to the saturated acyl CoA derivative.
仅用于科研。不用于诊断过程。未经明确授权不得转售。
篇参考文献 (0)
生物信息学
蛋白别名: 3-keto acyl-CoA synthase ELOVL2; elongation of very long chain fatty acids (FEN1/Elo2, SUR4/Elo3, yeast)-like 2; Elongation of very long chain fatty acids protein 2; elongation of very long chain fatty acids-like 2; ELOVL FA elongase 2; ELOVL family member 2; ELOVL fatty acid elongase 2; sequence similarity to Cig30 2; unnamed protein product; Very long chain 3-ketoacyl-CoA synthase 2; Very long chain 3-oxoacyl-CoA synthase 2; Very long chain fatty acid elongase 2; very-long-chain 3-oxoacyl-CoA synthase 2
基因别名: AI317360; ELG3; ELOVL2; SSC2
UniProt ID: (Human) Q9NXB9, (Rat) D4A612, (Mouse) Q9JLJ4
Entrez Gene ID: (Human) 54898, (Rat) 498728, (Mouse) 54326